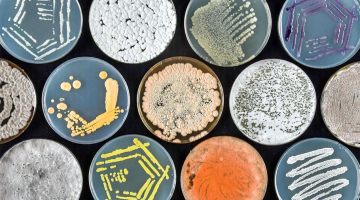

Aphea.Bio biedt landbouw alternatief voor pesticiden en meststoffen
Aphea.Bio ontwikkelt alternatieven voor schadelijke chemische pesticiden en synthetische meststoffen. Het bedrijf uit Gent baant zo mee de weg naar een meer duurzame landbouw. CEO Isabel Vercauteren: “Onze producten zijn geschikt voor conventionele landbouw en kunnen op exact dezelfde manier ingezet worden.” VLAIO steunde Aphea.Bio via verschillende onderzoeks- en ontwikkelingsprojecten, Baekeland- en innovatiemandaten, en de oproep ‘piloottraject bio-gebaseerde toepassingen’.

Nood aan duurzame producten
De chemische en synthetische producten die momenteel in de landbouw gebruikt worden, zijn allesbehalve duurzaam. CEO Isabel Vercauteren legt uit: “Het proces om synthetische meststoffen te maken is heel intensief, je hebt veel aardgas en hoge temperaturen nodig. Maar het gebruik is nog veel problematischer: de producten komen in waterlopen en de atmosfeer terecht. Daarnaast zijn chemische pesticiden ook nog eens nefast voor de gezondheid van de landbouwer.”

Chemische en synthetische producten komen in waterlopen en de atmosfeer terecht.
Aphea.Bio werd in 2017 opgericht vanuit de nood aan biologie-gebaseerde producten voor tarwe en maïs. Isabel: “Aphea.Bio ontstond als spin-off van het Vlaams Instituut voor Biotechnologie (VIB). We brachten knowhow van KU Leuven en UGent samen, wat toch uniek is. Isabel zelf heeft een doctoraat in de biologie aangevuld met jarenlange business development ervaring bij Bayer CropScience.

Gewassen doen groeien en beschermen
De focus van Aphea.Bio ligt op microbiële producten. Dit zijn natuurlijk voorkomende organismen zoals bacteriën, schimmels en giststammen. Isabel: “We zoeken die rondom ons, isoleren ze en ontwikkelen ze verder in een product”. Als alternatief voor meststoffen ontwikkelt Aphea.Bio biostimulanten of groeibevorderaars. Isabel legt uit: “De biostimulanten worden op de zaden als een coating aangebracht. Voor ze geplant worden, krijgen ze een fijn laagje van micro-organismen dat hen helpt om te groeien en om moeilijke periodes te overbruggen. Denk aan een gebrek aan voedingsstoffen, stikstof of fosfor, maar ook droogteperiodes.”
Daarnaast ontwikkelt Aphea.Bio biocontroleproducten op basis van natuurlijke micro-organismen om gewassen te beschermen. Die controleproducten worden net als conventionele producten ontwikkeld in verspuitbare oplossingen tegen plagen. Isabel: “Onze producten zijn geschikt voor conventionele landbouw en kunnen op exact dezelfde manier ingezet worden. Zo hoeft de landbouwer geen veranderingen te maken, zoals andere spuitkoppen of tractoren. We sluiten zo goed mogelijk aan op het schema dat de landbouwer gewoon is.”

Onze producten zijn geschikt voor conventionele landbouw en kunnen op exact dezelfde manier ingezet worden.
Eerste product op de markt
De eerste biostimulant voor tarwe is sinds deze zomer op de markt. Via een distributeur gaat die naar landbouwers. Een biostimulant voor maïs en een bio-bestrijdingsmiddel zullen snel volgen. Isabel: “We zijn intussen ook bezig met nieuw onderzoek. We werken aan nieuwe producten die ingezet kunnen worden tegen insecten en onkruiden en zijn gestart met het valideren van onze producten in bepaalde groente- en fruitsoorten, zoals courgettes of bessen.”
VLAIO steun
Aphea.Bio deed sinds de start meermaals beroep op VLAIO voor ondersteuning bij hun onderzoek. Isabel: “De steun gaf ons de mogelijkheid om wat meer risico te nemen en ook andere pistes met veel potentieel te onderzoeken. Zonder VLAIO steun ging dit niet gelukt zijn. Ook de samenwerking is steeds heel constructief.“ Aphea.Bio kreeg onder meer een Baekelandmandaat om meer inzicht te verwerven in de biologische controle van schimmelziekten in tarwe. Binnen de oproep ‘piloottraject bio-gebaseerde toepassingen’ kregen ze steun om de productie en formulatie van de meest beloftevolle biofungicide-stammen op te schalen met het oog op een vermarktbaar product. Momenteel loopt ook een ontwikkelingsproject waar Aphea.Bio vijf biofungicide micro-organismen verder optimaliseert en ontwikkelt tot één biofungicideproduct tegen 3 tarweschimmels.

De steun gaf ons de mogelijkheid om wat meer risico te nemen en ook andere pistes met veel potentieel te onderzoeken. Zonder VLAIO steun ging dit niet gelukt zijn. Ook de samenwerking is steeds heel constructief.
Groeien en internationaliseren
Aphea.Bio rondde net een nieuwe financieringsronde af waarmee ze de komende drie jaar hun producten verder kunnen vermarkten in Europa en daarbuiten. Isabel: “Onze ambitie is globaal, we willen ook uitbreiden naar Amerika en Brazilië”. Verder zitten er nieuwe R&D projecten in de pipeline, en breiden ze uit met een nieuw kantoor en nieuwe werknemers. Isabel: “We openen binnenkort een nieuwe faciliteit voor ons development team omdat we uit onze voegen aan het barsten zijn. Momenteel zijn we met 50, maar tegen eind 2024 gaan we richting 70 werknemers.”

Wat is de volgende stap die jij wil zetten met je bedrijf?
Als ambitieuze ondernemer wil je maar één ding: dat je zaak vooruit gaat. Daarom investeer je én daarom innoveer je. Maar ook al heb je bakken ervaring, toch blijf je met heel wat vragen zitten.
VLAIO is jouw gids bij de realisatie van je plannen. Wij zijn een kritisch klankbord en brengen sterktes en zwaktes in kaart. Daarbij geven we ook concreet advies over subsidies en financiering. En we brengen je in contact met de juiste experten.
Heb je net als Aphea.Bio een vernieuwend idee, maar moet je nog uitdagingen overwinnen bij de ontwikkeling van die innovatie? Dien dan een ontwikkelingsproject in.